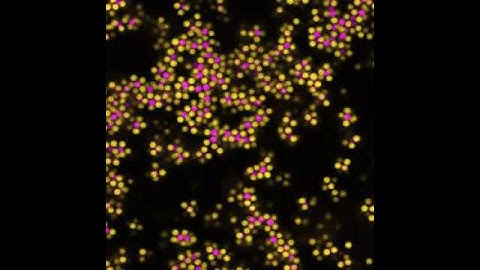
Colloidal Gelation (2)

⬇ DOWNLOAD NOW
Kalau muncul iklan pop-up, tutup lalu klik tombol kembali
Download lagu Formation of colloidal gel via arrest of spinodal decomposition in a colloid-polymer mixture secara gratis hanya untuk keperluan promosi. Dukung artis favorit kamu dengan membeli musik original di iTunes atau platform resmi lainnya.
 Long term stability of a colloidal gel
Long term stability of a colloidal gel
 Solution Suspension Colloid
Solution Suspension Colloid
Colloidal Gelation (2)
Colloidal Gelation (2)
 Colloidal Gelation
Colloidal Gelation
 Colloids and the depletion interaction
Colloids and the depletion interaction
 #20 Colloid Polymer Mixtures | Colloids & Surfaces
#20 Colloid Polymer Mixtures | Colloids & Surfaces
 Tyndall effect | Scattering of light
Tyndall effect | Scattering of light
 Colloidal fluid rotated in 3D
Colloidal fluid rotated in 3D